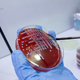

Legionela v domovih za ostarele naj ne bi ogrožala njihovih prebivalcev

Minister za solidarno prihodnost Simon Maljevac se je seznanil s stanjem v ljubljanskih socialnovarstvenih zavodih, v katerih so potrdili okužbo z legionelo. Ugotavlja, da so vodstva zavodov nemudoma ukrepala v …
![]() Svet24 · 1L
Svet24 · 1L
Znano, kako je s stanovalci domov, ki so se okužili z neugodno bakterijo

Minister za solidarno prihodnost Simon Maljevac se je seznanil s stanjem v ljubljanskih socialnovarstvenih zavodih, v katerih so potrdili okužbo z legionelo. Minister ugotavlja, da so vodstva zavodov nemudoma ukrepala …
Slovenske novice · 1L
V domovih z legionelo zagotavljajo, da se stanovalci počutijo dobro
Minister za solidarno prihodnost Simon Maljevac se je seznanil s stanjem v ljubljanskih socialnovarstvenih zavodih, v katerih so potrdili okužbo z legionelo. Minister ugotavlja, da so vodstva zavodov nemudoma ukrepala …
![]() 24ur · 1L
24ur · 1L
NIJZ: Slovenija ima odlično vzpostavljene protokole za obravnavo bolnikov z legionelozo

V Sloveniji so odlično vzpostavljeni protokoli za ukrepanje v primeru okužb z legionelo pri osebah, ki bivajo v domovih za starejše in drugih javnih ustanovah, je ob večjem številu okužb …
![]() RTV Slovenija · 1L
RTV Slovenija · 1L
Okužbe z legionelo tudi v bančni ustanovi

Rezultati zadnjega pregleda v upravni stavbi SKB banke so pokazali, da je v sistemu prisotna legionela. V upravi SKB redno opravljajo preventivne preglede pitne vode, v prihodnjih dneh je predvidena …
![]() Siol.net · 1L
Siol.net · 1L
V Ljubljani devet primerov okužbe z nevarno bakterijo

Previdno! 💧 Po poročanju Televizije Slovenija (TVS) so legionelozo, ki jo povzroča omenjena bakterija, potrdili pri oskrbovancih več socialnovarstvenih zavodov na območju Ljubljane. Na NIJZ ne razkrivajo, za katere zavode …
![]() Metropolitan.si · 1L
Metropolitan.si · 1L
Previdno, v Ljubljani izbruh nevarne bakterije, vzpostavljen izredni nadzor

Na Nacionalnem inštitutu za javno zdravje (NIJZ) so v zadnjem obdobju potrdili devet primerov okužb z bakterijo legionelo, so pojasnili za STA. Po poročanju Televizije Slovenija (TVS) so legionelozo, ki …
![]() Žurnal24 · 1L
Žurnal24 · 1L
V domovih za starejše potrdili devet okužb z legionelozo

Na ministrstvu za solidarno prihodnost zagotavljajo, da so domovi varni. Na Nacionalnem inštitutu za javno zdravje (NIJZ) so v zadnjem obdobju potrdili devet primerov okužb z bakterijo legionelo, so pojasnili …
![]() Delo · 1L
Delo · 1L
V več domovih za starejše potrdili okužbe oskrbovancev z legionelozo

Na Nacionalnem inštitutu za javno zdravje (NIJZ) so v zadnjem obdobju potrdili devet primerov okužb z bakterijo legionelo. Legionelozo, ki jo povzroča omenjena bakterija, so potrdili pri oskrbovancih več socialnovarstvenih …
![]() 24ur · 1L
24ur · 1L
V več domovih za starejše potrdili skupno devet okužb oskrbovancev z legionelozo

Na Nacionalnem inštitutu za javno zdravje (NIJZ) so v zadnjem obdobju potrdili devet primerov okužb z bakterijo legionelo, so pojasnili za STA. Po poročanju Televizije Slovenija (TVS) so legionelozo, ki …
![]() Primorske novice · 1L
Primorske novice · 1L
V več domovih za starejše na območju Ljubljane okužbe z legionelo

Po informacijah TV Slovenija so bile februarja v več socialno varstvenih zavodih potrjene okužbe oskrbovancev z bakterijo legionelo. NIJZ je potrdil informacije o devetih primerih okužbe, a ne razkriva za …
![]() RTV Slovenija · 1L
RTV Slovenija · 1L
ljubljanadomovi za starejšezdravstveni nadzorokužbelegionela
Z obiskom in uporabo spletnega mesta soglašate s piškotki.